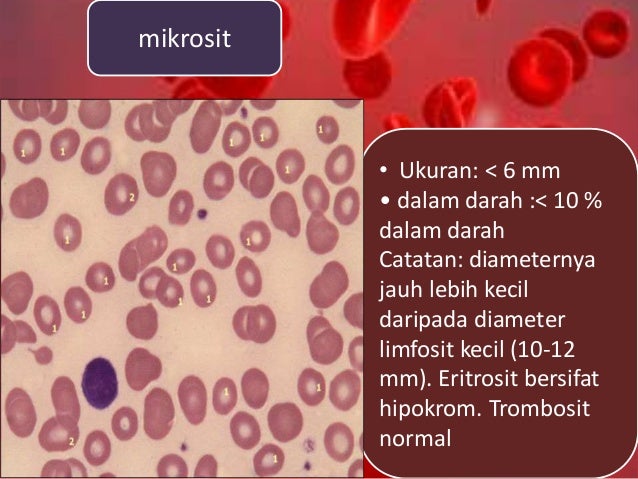
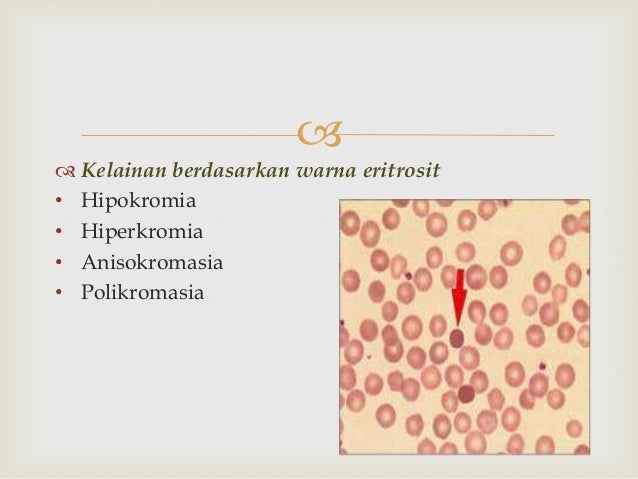

Ukuran selang, ukuran selotip, ukuran selang air, ukuran selotip bening, ukuran kawat seling, dimensi ukuran selang 3/4, ukuran sel pati kentang pdf, ukuran sel epitelium pipi pdf, ukuran selang bensin mobil great corolla,
Heme Lect Test 2 At Argosy - Studyblue via www.studyblue.com Biologi 10 Virus via www.slideshare.net Jaringan Darah (blood Tissue) via www.slideshare.net Eritrosit (sel Darah Merah) via www.slideshare.net Sel Darah Merah via www.slideshare.net Sel Darah Merah via www.slideshare.net Soal No 17 Un 2011 Transportasi Beriman,berilmu,berakal via masihtertulis.blogspot.com Umeyme Sevenfoldism Kuduscityofevil: Menghitung Jumlah via umeyme.blogspot.com Rubrisit - Wikipedia Bahasa Indonesia, Ensiklopedia Bebas via id.wikipedia.org Hematologi ~ Catatan Kuliah Ku via priyantoamak.blogspot.com Sel Darah Merah via www.slideshare.net Sel Darah Merah via www.slideshare.net Biologi Gonzaga: Pre Test System Transporatsi via biologigonz.blogspot.com Random Image
Related Posts To Ukuran Sel Eritrosit
Ukuran Sel Eritrosit 2019-11-21T19:28:00-08:00
Rating: 4.5
Posted by:
hanisohee